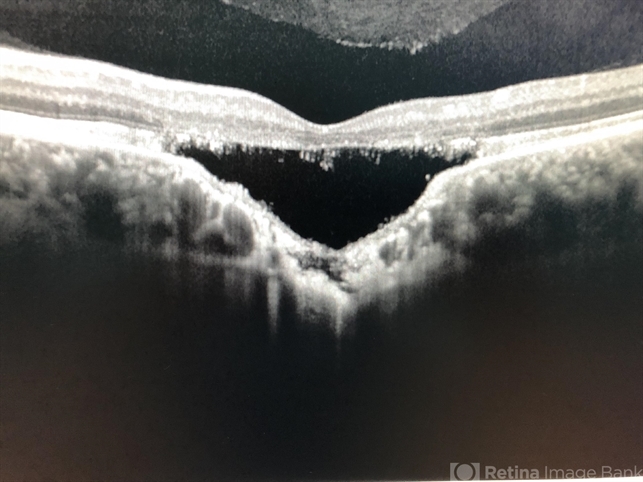

File number: 30076
Comments
-
Selma Milisic (November 10 2019)
Excellent photography...
-
Aristofanes Canamary jr (June 4 2019)
Very nice photograph
Sign in to comment.
-
By Nelson Chamma Capelanes, MD
Promedica Indaiatuba / UPO Oftalmologia
Co-author(s): Caio Regatieri, MD, PhD - Uploaded on Jun 2, 2019.
- Last modified by Caroline Bozell on Jun 4, 2019.
- Rating
- Appears in
- Miscellaneous
- Condition/keywords
- chronic central serous chorioretinopathy (CSCR), choroidal excavation, pachychoroid
- Photographer
- Nelson Chamma Capelanes, Promacula, Brazil
- Imaging device
-
Optical coherence tomography system
Heidelberg Spectralis SD-OCT - Description
- SD-OCT of a 32-year-old woman showing a subfoveal choroidal excavation associated with chronic central serous chorioretinopathy.